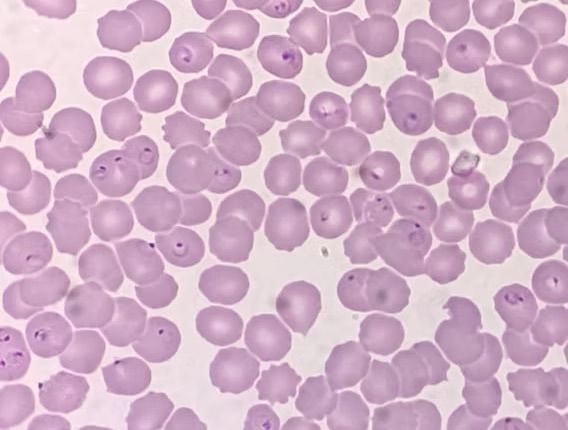
Mikroskopische Ansicht eines Blutausstrichs, der zahlreiche rote Blutkörperchen zeigt mit ringförmige Malariaparasiten.

Das Tropeninstitut ist Ihre spezialisierte Anlaufstelle für Reise- und Tropenmedizin in Niederösterreich und im Süden Wiens. Unter der Leitung von OA Dr. Erich Pawelka sind wir für alle medizinischen Fragestellungen rund ums Reisen für Sie da. Im Rahmen der Reise- und Impfberatung evaluieren und identifizieren wir mögliche Risiken Ihres geplanten Auslandsaufenthalts, um diese zu minimieren. Mit hocheffektivem und gut verträglichem Impfstoffen kann das Risiko für viele Infektionskrankheiten auf ein Minimum reduziert werden. Darüber hinaus berücksichtigen wir auch spezielle Herausforderungen wie Reisen in große Höhen, eingeschränkte hygienische Bedingungen oder Reisen mit chronischen Erkrankungen, um Sie optimal vorzubereiten. Wir stehen Ihnen natürlich auch bei Problemen nach Reiserückkehr jederzeit zur Verfügung.
Leistungen
Individuelle Reiseberatung & Tropenmedizin
Reisen in tropische und subtropische Regionen bringen besondere gesundheitliche Herausforderungen mit sich. Eine fundierte Reiseberatung umfasst weit mehr als Impfungen: Wir beraten Sie zu Infektionsrisiken, Hygienemaßnahmen, Insektenschutz sowie zum sicheren Umgang mit bestehenden Erkrankungen.
Im Tropeninstitut beachten wir alle Aspekte Ihrer Reise. Egal ob Kurzzeit- oder Langzeitaufenthalt, Katastropheneinsatz oder Luxusurlaub, Tauchen, Wandern oder Städtetrip, einmalige Reise- Weltenbummler oder langfristiger Umzug. Unser Ziel ist es Sie bestmöglich auf Ihre Reise vorzubereiten.
Impfberatung & Impfungen
Die Impfberatung ist ein zentraler Bestandteil der Reisemedizin. Sie trägt wesentlich dazu bei, schwere und potenziell lebensbedrohliche Infektionskrankheiten zu vermeiden. Neben spezifischen Reiseimpfungen überprüfen wir auch Ihre Standardimpfungen und frischen diese bei Bedarf auf.
Wir planen Ihre Beratungstermine bewusst großzügig, um uns genug Zeit für Ihre Anliegen zu nehmen und Sie ausführlich beraten zu können. Impfempfehlungen erfolgen ausschließlich auf medizinischer Grundlage – unabhängig von wirtschaftlichen Überlegungen.
Reiserückkehrer & medizinische Abklärung
Auch nach einer Reise können gesundheitliche Beschwerden auftreten. Symptome wie Fieber, Durchfall oder Hautausschläge sollten ernst genommen und abgeklärt werden. Wir bieten Ihnen eine gezielte Diagnostik und Betreuung für Reiserückkehrer.
Besonders wichtig: Bei Fieber nach einem Aufenthalt in einem Malariagebiet ist eine sofortige medizinische Abklärung erforderlich.
Infektiologische Abklärungen
Neben der Tropenmedizin bieten wir umfassende infektiologische Abklärungen nach aktuellem wissenschaftlichen Stand an. Dank der klinischen Erfahrung und der persönliche Betreuung erhalten Sie eine fundierte Diagnostik und individuell abgestimmte Therapie. Infektiologische Abklärungen erfolgen ausschließlich durch OA Dr. Erich Pawelka persönlich.
Erfahrung, Zeit und persönliche Betreuung
Als Facharzt für Innere Medizin und Infektiologie mit Schwerpunkt Tropenmedizin verbinde ich langjährige klinische Erfahrung mit individueller Patientenbetreuung. In meiner Wahlarztpraxis in Mödling nehme ich mir bewusst Zeit, um Ihre Anliegen sorgfältig zu analysieren und verständlich zu besprechen.
Moderne Ansätze wie telemedizinische Beratung ermöglichen zusätzlich eine flexible Betreuung. Mein Ziel ist es, Ihnen eine medizinische Versorgung auf höchstem Niveau zu bieten – persönlich, evidenzbasiert und auf Ihre Bedürfnisse abgestimmt.
Während reisemedizinische Beratungen an Vertretungs- und Urlaubstagen auch durch ein kleines, persönlich ausgewähltes Team an qualifizierten Kolleg:innen erfolgen können, werden infektiologische Abklärungen ausschließlich von mir persönlich durchgeführt.
OA Dr. Erich Pawelka

Häufige Fragen zur Reise- und Impfberatung
Welche Impfungen benötige ich für meine Reise?
Das hängt vom Reiseziel, der Reisedauer und den geplanten Aktivitäten ab. Im Rahmen der individuellen Impfberatung legen wir gemeinsam mit Ihnen fest, welche Impfungen sinnvoll und notwendig sind.
Kann ich bei meinem Beratungstermin auch gleich geimpft werden?
Ja, im Rahmen der Reiseberatung werden im Regelfall auch gleich die ersten Impfungen verabreicht. Alle Impfungen sind vor Ort lagernd. Mitgebrachte Impfungen, insbesondere Gelbfieberimpfungen, können nicht verabreicht werden.
Wie gut sind die Impfungen verträglich und kann ich mehrere Impfungen auf einmal bekommen?
Die meisten modernen Impfstoffe sind von exzellenter Verträglichkeit und bis auf wenige Ausnahmen können mehrere Impfstoffe zeitgleich verabreicht werden. Genaueres erfahren Sie bei Ihrem Beratungstermin, an dem wir auch einen individuellen Impfplan erstellen.
Ist eine reisemedizinische Beratung notwendig?
Ja, insbesondere bei Fernreisen oder Aufenthalten in tropischen Regionen. Eine professionelle Beratung hilft, gesundheitliche Risiken frühzeitig zu erkennen und gezielt zu vermeiden.
Wie gefährlich ist Malaria und brauche ich eine Prophylaxe?
Malaria ist eine potenziell lebensbedrohliche Erkrankung. Ob eine medikamentöse Prophylaxe notwendig ist, entscheiden wir individuell anhand Ihres Reiseziels und Ihrer Reiseroute.
Kann ich mich gegen Dengue-Fieber impfen lassen?
Ja, es steht eine Impfung zur Verfügung. Ob diese für Sie sinnvoll ist, klären wir gemeinsam im Rahmen der Reiseberatung.
Wann ist eine Tollwutimpfung sinnvoll?
Eine Tollwutimpfung empfehlen wir insbesondere bei erhöhtem Risiko für Tierkontakte oder eingeschränkter medizinischer Versorgung im Reiseland – immer basierend auf einer individuellen Risikobewertung.
Was sollte ich bei Reisen mit chronischen Erkrankungen beachten?
Eine sorgfältige Vorbereitung ist hier besonders wichtig. Wir stimmen Medikamente, Impfungen und mögliche Risiken individuell auf Ihre Situation ab.
Was tun bei Beschwerden nach der Reise?
Bei Fieber oder unklaren Symptomen nach einer Reise sollte rasch eine medizinische Abklärung erfolgen. Wir unterstützen Sie dabei mit gezielter Diagnostik für Reiserückkehrer.